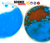
Ferrofluid Nanotechnology Kit

Warning
WarningHAZARDOUS CHEMICAL: This kit contains hazardous chemicals. Not for children under the age of 15. For use under adult supervision. Read warning labels carefully.
CHOKING HAZARD: Small parts. Not for children under 3 years. Adult supervision required.
MAGNETS: This product contains very strong magnets and are a pinching hazard. Keep out of reach of young children. Keep away from pacemakers and internal medical devices.
- Economy Shipping is $8.95 for most orders (some products are not eligible).
- FREE Economy Shipping on orders $100+ with code 100FREESHIP.
- Orders with 1-day or 2-day shipping placed by 1:00 pm MST ship the same day. All other orders typically ship the next business day.
- See Shipping Information for more details.
- Returns: Return unused products within 60 days. To get started, see our return policy.